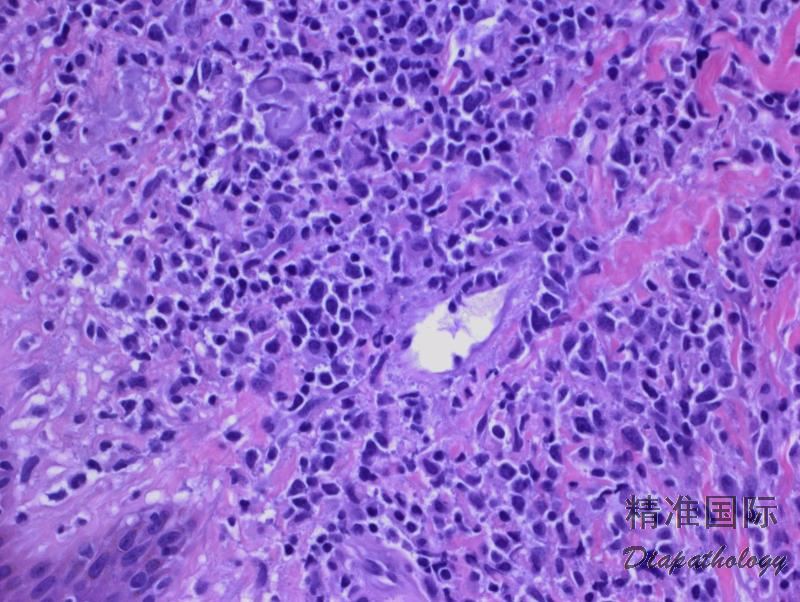

结外 NK/T 细胞淋巴瘤,鼻型
Extranodal NK/T Cell Lymphoma, Nasal Type
概述:
结外 NK/T 细胞淋巴瘤系结外淋巴瘤,鼻腔是最常见原发部位,其典型特征表现为血管中心性侵润,损伤破坏血管壁,组织显著坏死,细胞毒表型及与 EBV 高度相关。这类肿瘤大部分是真正的 NK 细胞肿瘤,但也包括一些具有细胞毒性 T 细胞表型的肿瘤,它们有相似的临床病理特征,故称之为 NK/T 细胞淋巴瘤。
诊断要点:
几乎只见于成年人(50 岁左右),在亚洲人、墨西哥人和南美土著人中发病率较高。
以发病部位不同分为鼻 NK/T 细胞淋巴(nasal NK/T cell lymphoma)和鼻外 NK/T 细胞淋巴(extranasal NK-T cell lymphoma)。前者累及鼻腔、鼻咽或上呼吸消化道,并常播散至邻近解剖结构包括骨组织;后者少见,常见累及部位包括皮肤、胃肠道、睾丸、肺、眼和软组织(这些部位也是前者疾病过程中易于播散的部位)。
肿瘤细胞弥漫侵润伴组织地图样坏死,常累及血管(血管中心性生长),致管壁损伤、纤维素样坏死。散在凋亡小体、坏死细胞残影、核碎屑及纤维素性和血性渗出易见。
肿瘤细胞大小因病例而异,可以是小型细胞,也可以是中等或大细胞或混合大小细胞。小细胞核轮廓不规则,染色质密集、核仁不明显,胞质淡染,少量至中等。中等大小细胞核呈圆形或有不规则核皱褶,染色质呈颗粒状,核仁小,胞质含量中等,淡染至透明。大细胞表现为核圆形,空泡状或颗粒状染色质,有明显核仁。
免疫表型:肿瘤细胞 CD56+、CD2+、胞质 CD3+,TIA-1+、粒酶 B+、穿孔素+,表面 CD3-、CD4-、CD5-、CD8-、TRαβ-、TRγδ-,CD57-、CD16-,部分病例(30%)CD30+(弱或局灶,主要见于大细胞)。少数病例为细胞毒 T 细胞表型,表达的抗原常包括 CD5. CD8. TCR(αβ 或 γδ)。
EBER+。几乎见于所有病例(少数病例 CD56-,但 EBER 必需是阳性才能诊断)。
大部分病例无 TCR 基因克隆性重组(少数病例 T 细胞来源可阳性)。有重现性基因突变,累及的基因可包括 JAK/STAT 通道、RAS 家族、肿瘤抑制基因等。

免疫组织化学染色:
肿瘤细胞 CD56+、CD2+、胞质 CD3+,TIA-1+、粒酶 B+、穿孔素+,表面 CD3-、CD4-、CD5-、CD8-、TRαβ-、TRγδ-,CD57-、CD16-,CD30-/+(弱或局灶,主要见于大细胞)。
鉴别诊断:
Wegener 肉芽肿 :除上呼吸道外,常同时累及肺和肾脏。组织学表现为肉芽肿及存在多核巨细胞和混合炎性细胞包括嗜酸细胞、组织细胞和浆细胞。无异型细胞侵润。EBER 阴性。
淋巴瘤样肉芽肿病 (LyG):主要累及肺部,有时也侵犯脑或皮肤。部分患者常有免疫低下病史。肿瘤细胞呈血管中心性生长,肿瘤细胞系数量不等的 CD20+、EBER+的非典型 B 细胞,混合以丰富的背景反应性 T 细胞。
皮下脂膜炎样 T 细胞淋巴瘤 (SPTL):累及皮下组织,极少侵犯真皮。血管中心性生长少见,异型肿瘤细胞常环绕脂肪细胞生长,表面 CD3+、CD8+、CD56-,EBER-。
原发性皮肤 γ/δT 细胞淋巴瘤 :组织形态学与 SPTL 相似,但临床更具侵袭性。肿瘤细胞表达 CD3. CD56,不表达 CD4. CD8. CD5,EBER-。
母细胞性浆细胞样树突细胞肿瘤( BPDN):形态单一、中等大小的母细胞样细胞浸润,核圆形或卵圆形,核膜薄,染色质纤细,一般无血管浸润和坏死。肿瘤细胞表达 CD56. CD4. CD123. TCL1,EBER-。
结性 NK/T 细胞淋巴瘤:有报道。肿瘤原发于淋巴结,细胞弥漫生长,形态单一,无血管中心性坏死。一般认为是外周 T 细胞淋巴瘤的变异形。
预后:
鼻 NK/T 细胞淋巴瘤预后情况不等,对治疗反应不一;鼻外 NK/T 淋巴瘤预后不良,生存期短。
